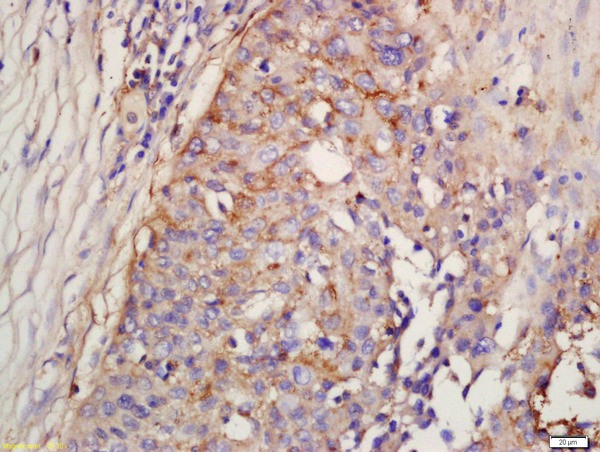
Factor D/Adipsin Antibody in Immunohistochemistry (Paraffin) (IHC (P))

Search
Bioss
Factor D/Adipsin Polyclonal Antibody
{{$productOrderCtrl.translations['antibody.pdp.commerceCard.promotion.promotions']}}
{{$productOrderCtrl.translations['antibody.pdp.commerceCard.promotion.viewpromo']}}
{{$productOrderCtrl.translations['antibody.pdp.commerceCard.promotion.promocode']}}: {{promo.promoCode}} {{promo.promoTitle}} {{promo.promoDescription}}. {{$productOrderCtrl.translations['antibody.pdp.commerceCard.promotion.learnmore']}}
产品信息
BS-13130R
种属反应
宿主/亚型
分类
类型
抗原
偶联物
形式
浓度
规格
纯化类型
保存液
内含物
保存条件
运输条件
靶标信息
Complement factor D is a serine protease of the alternative pathway of complement activation. The protein is a single chain polypeptide with a molecular mass of 25 kDa. Factor D cleaves factor B bound to C3b, generating the alternative pathway C3 convertase C3bBb and releasing the Ba fragment.
仅用于科研。不用于诊断过程。未经明确授权不得转售。
篇参考文献 (0)
生物信息学
蛋白别名: 28 kDa adipocyte protein; Adipsin; C3 convertase activator; Complement factor D; complement factor D preproprotein; D component (adipsin) of complement; D component of complement (adipsin); DF; EC 3.4.21.46; Properdin factor D; unnamed protein product
基因别名: ADIPSIN; ADN; CFD; DF; PFD
UniProt ID: (Human) P00746, (Mouse) P03953
Entrez Gene ID: (Human) 1675, (Mouse) 11537